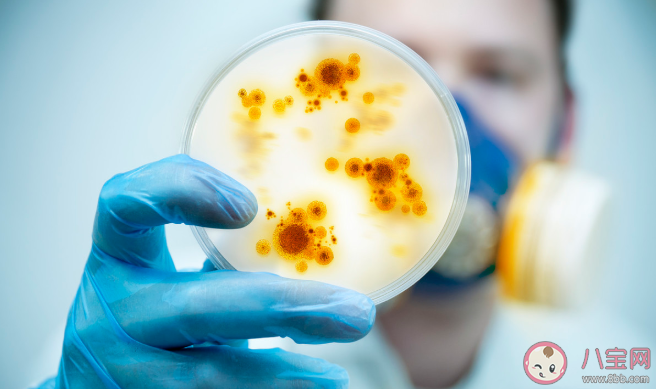
得了布病要怎么治療 得了布病多久能治好 得了布病要怎么治療 得了布病多久能治好

時(shí)間:2020-09-04 08:38:10來(lái)源:本站整理作者:xl點(diǎn)擊:
得了布病及時(shí)治療是非常關(guān)鍵的,及早治療能夠幫助更快恢復(fù),布魯氏桿菌進(jìn)入人體會(huì)有很大危害,那么,得了布病要怎么治療?得了布病多久能治好?下面八寶網(wǎng)小編就來(lái)說(shuō)說(shuō)。

1、抗菌藥和磺胺治療法
該法用以亞急性、亞急性癥狀,及其病發(fā)期發(fā)作的患者,即用以伴隨發(fā)燒、血細(xì)胞效價(jià)較高或細(xì)菌培養(yǎng)為呈陽(yáng)性的病人。其目地殺掉身體布氏桿菌。該菌是入侵到人體的體細(xì)胞內(nèi)存活,服藥時(shí)最好是采用可以進(jìn)到體細(xì)胞的藥品,便于消滅體細(xì)胞內(nèi)寄生的布氏菌,這一問(wèn)題現(xiàn)階段還未獲得處理。
2、脫敏療法
該法關(guān)鍵用以醫(yī)治病發(fā)期患者,以疲倦乏力、全身關(guān)節(jié)痛主導(dǎo),不伴隨發(fā)燒但布氏菌素皮內(nèi)超敏反應(yīng)實(shí)驗(yàn)呈陽(yáng)性的患者。臨床醫(yī)學(xué)上常用的特異性抗過(guò)敏藥品有醫(yī)治用的布氏菌苗,水解反應(yīng)素和溶菌素等,其抗過(guò)敏功效好,最近功效也較令人滿意,尤其是選用布氏菌苗醫(yī)治布病,世界各國(guó)現(xiàn)有很多年的歷史時(shí)間,迄今仍為很多人 強(qiáng)烈推薦。

及時(shí)治療最關(guān)鍵。
如果能及時(shí)按醫(yī)囑接受規(guī)范化治療,急性期患者中大多數(shù)可于3~6個(gè)月內(nèi)恢復(fù)健康。如果發(fā)病后3個(gè)月內(nèi)沒(méi)有及時(shí)治療,或者沒(méi)有按醫(yī)生要求堅(jiān)持用藥,就容易轉(zhuǎn)為慢性布病,不易治愈。
人得了布病后,布魯氏桿菌可以侵入人體各個(gè)部位,引起各器官組織發(fā)生病變,影響勞動(dòng)力和生活質(zhì)量,嚴(yán)重的可造成終身勞動(dòng)力喪失。
牲畜患病后,可導(dǎo)致大量母畜不孕、流產(chǎn),同時(shí)患病的牲畜可造成周?chē)h(huán)境污染,使得更多的牲畜患病,這不僅嚴(yán)重影響畜牧業(yè)的發(fā)展,更對(duì)乳、肉、皮、毛加工帶來(lái)無(wú)窮危害,而且還會(huì)影響人群的健康和當(dāng)?shù)氐慕?jīng)濟(jì)發(fā)展
人為什么會(huì)被感染?
1、經(jīng)皮膚粘膜接觸感染:如接羔、飼養(yǎng)、放牧、皮毛加工、屠宰、擠奶時(shí),在沒(méi)有做好個(gè)人防護(hù)情況下,直接接觸病畜或其排泄物、胎盤(pán)、流產(chǎn)物;也可間接接觸病畜污染的環(huán)境及物品(如水源、污染的空氣、土壤、草料、工具)而受染;
2、經(jīng)消化道感染:食用被布魯氏菌污染的食品、水或食生乳以及未熟的病羊、牛肉而感染;
3、經(jīng)呼吸道感染:打掃畜圈衛(wèi)生、飼養(yǎng)放牧?xí)r吸入了被布魯氏菌污染的空氣飛沫、塵埃而感染。
以上就是有感全部?jī)?nèi)容介紹,想了解更多信息請(qǐng)繼續(xù)關(guān)注。
孩子乙型流感多久能恢復(fù) 孩子乙流幾天能自己好最近的乙型流感讓很多家長(zhǎng)很肯恐慌,特別是已經(jīng)在醫(yī)院看過(guò)醫(yī)生吃過(guò)……
新冠肺炎命名COVID-19是什么意思 COVID-19是什么意思 小孩生病大人心情語(yǔ)錄 小孩生病大人心情感概句子 新型冠狀病毒感染了一定會(huì)發(fā)熱嗎 新型冠狀病毒前期的癥狀有哪些 新型冠狀病毒什么時(shí)候會(huì)結(jié)束 新型冠狀病毒什么天氣容易傳播 孩子生病大人的心情短語(yǔ)說(shuō)說(shuō) 擔(dān)心孩子生病的句子說(shuō)說(shuō)朋友圈
孩子生病大人的心情短語(yǔ)說(shuō)說(shuō) 擔(dān)心孩子生病的句子說(shuō)說(shuō)朋友圈
網(wǎng)友跟帖
Copyright 2015-2020 8bb.com 〖八寶網(wǎng)〗 版權(quán)所有 鄂ICP備19016373號(hào)-1
聲明: 本站文章均來(lái)自互聯(lián)網(wǎng),不代表本站觀點(diǎn) 如有異議 請(qǐng)與本站聯(lián)系 本站為非贏利性網(wǎng)站 不接受任何贊助和廣告
網(wǎng)友評(píng)論僅供其表達(dá)個(gè)人看法,并不表明八寶網(wǎng)立場(chǎng)。